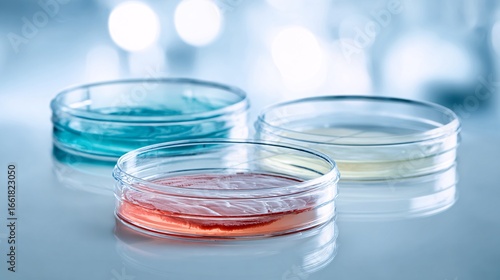
Petri dishes with red, blue, and yellow agar for microbiology research

More from this collection
Similar Wallpaper designs
Petri Dishes With Red, Blue, And Yellow Agar For Microbiology Research

Petri Dishes Featuring Colorful Microbial Cultures On White Laboratory Workbench

Glass Petri Dishes On A Reflective Surface, Containing Colorful Liquids, Representing Chemistry And Biology Innovation






